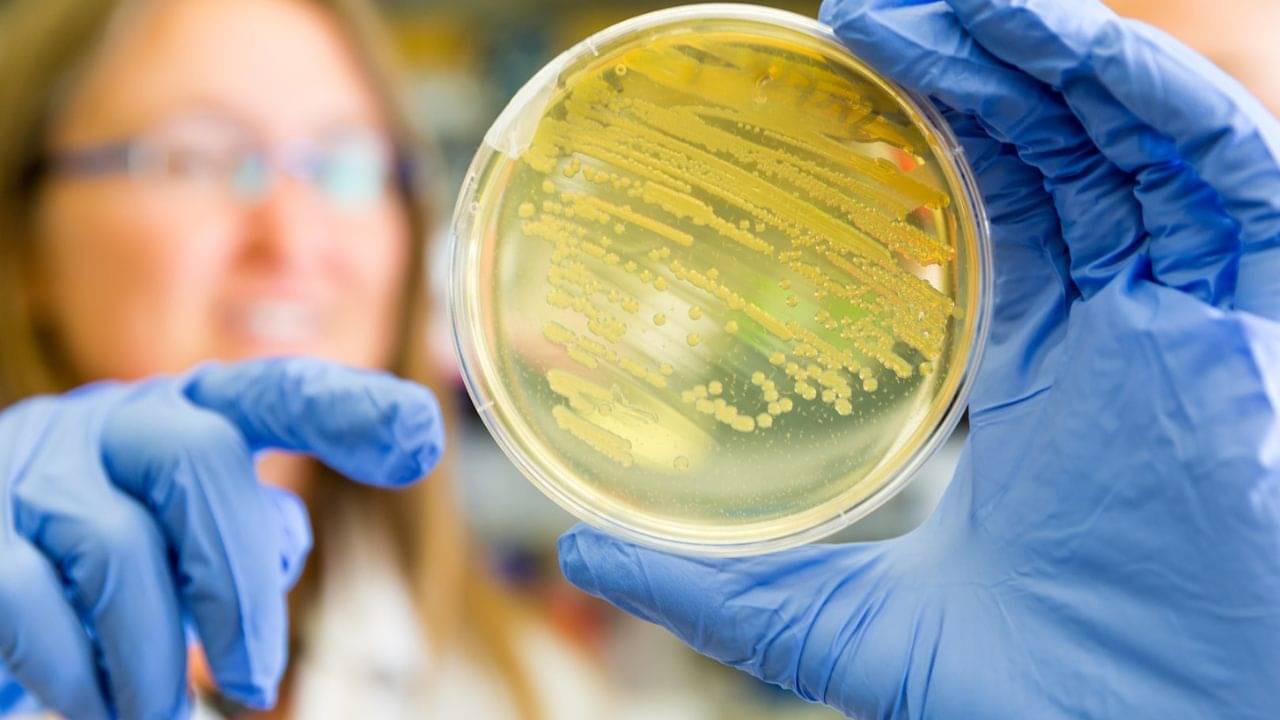
Career Tips: Biological Science-Nutrition-Psychology, উচ্চ মাধ্যমিকের পড়ুয়াদের জন্য কেন গুরুত্বপূর্ণ এই কম্বিনেশন?

Biological Science + Nutrition + Psychology একাদশ এবং দ্বাদশ শ্রেণীর ছাত্র ছাত্রীদের পড়াশোনার জন্য এই ৩ বিষয়ের কম্বিনেশন বেশ ভাল, মত কেরিয়ার বিশেষজ্ঞদের। একাধিক স্কুলে এই কম্বিনেশন পাওয়া যায়। কিন্তু কেন এই বিষয় নিয়ে পড়বেন? কী লাভ হবে? রইল বিস্তারিত।
এই তিনটি বিষয় মিলিয়ে ছাত্র ছাত্রীরা শরীরের গঠন, রোগ-প্রতিরোধ, খাদ্যাভ্যাস এবং মানসিক স্বাস্থ্যের মধ্যে সম্পর্ক বুঝতে শিখবেন। এটি বিশেষভাবে গুরুত্বপূর্ণ। বর্তমানে, যেখানে লাইফস্টাইল ডিজিজ যেমন – ডায়াবেটিস, অবসাদ, স্থূলতার মতো রোগের প্রকোপ বাড়ছে সেক্ষেত্রে এই ধারণা অত্যন্ত গুরুত্বপূর্ণ।
যারা ভবিষ্যতে ডাক্তার, নিউট্রিশনিস্ট, ফিজিওথেরাপিস্ট, সাইকোলজিস্ট বা পাবলিক হেল্থ এক্সপার্ট হতে চান, তাদের জন্য এটি একটি উপযুক্ত কম্বিনেশন।
Psychology শেখায় কীভাবে আমাদের চিন্তা, অনুভূতি ও আচরণ শরীরের উপর প্রভাব ফেলে এবং কীভাবে সেগুলোর বৈজ্ঞানিক ব্যাখ্যা করা যায়। এটি Mental Health বোঝার জন্য গুরুত্বপূর্ণ।
জেনারেল ওয়েলনেস ও ফিটনেস ইন্ডাস্ট্রির জন্যও উপযুক্ত।
যারা ভবিষ্যতে ডায়েটিশিয়ান, ফিটনেস কোচ, হেল্থ ব্লগার, হোলিস্টিক থেরাপিস্ট বা ওয়েলনেস কনসালটেন্ট হতে চান তাদের জন্য এই কম্বিনেশন দারুণভাবে প্রাসঙ্গিক।
এই তিনটি বিষয়ের নিয়ে ইন্টারডিসিপ্লিনারি রিসার্চের বিশাল সুযোগ রয়েছে। যেমন Nutritional Psychology, Psychoneuroimmunology ইত্যাদি।
কারা এই কম্বিনেশন বেছে নেবেন?
যারা বিজ্ঞান ও মানব আচরণ উভয় বিষয়েই আগ্রহী। যারা চিকিৎসা, মনোবিদ্যা, নিউট্রিশন, বা হেলথ-সায়েন্সে ভবিষ্যৎ গড়তে চান। যারা মানুষকে স্বাস্থ্যবান ও সুখী রাখার পেশায় যেতে চান। যাদের পর্যবেক্ষণ, বিশ্লেষণ ও সহানুভূতির ক্ষমতা ভালো। যারা শুধু ডাক্তারি নয়, আরও বিস্তৃত হেলথ কেয়ার ক্যারিয়ার খুঁজছেন তাঁদের জন্য ভাল।
বুধবার উচ্চ মাধ্যমিকের রেজাল্ট। সবার আগে রেজাল্ট জানতে এখনই নথিভুক্ত করে ফেলুন এই ফর্মে-